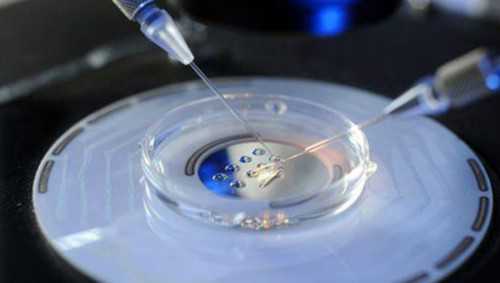
南京借卵中心 南京军区南京总医院体外受精成功率调查 ‘怀孕男孩的最初症状

南京借卵中心是知名助孕机构,正规有偿捐卵,为您国内外试管婴儿咨询一站式业务.
南京一代试管费用总共多少?
第一代试管婴儿针对男性精子正常,女方有问题的不孕症,例如输卵管问题,卵巢问题等等。南京当地做试管婴儿的费大概是3-5万元不等,这是普通一代试管婴儿的费用,于每个地区的消费水平和人均收入水平不一样,所以做试管婴儿所产生的费用也不完全一样。南京是一个消费水平比较高的地区,在南京当地做试管婴儿的费用一般都在3至5万元不等。二代试管费用是4-6万左右,三代试管婴儿费用是在6万元-10万元左右。
南京军区南京总医院体外受精成功率调查
南京军区南京总医院试管婴儿成功率大概在40%-60%。这家大医院在试管婴儿治疗方面积累了很多工作经验。同时,医院首次研发了微创试管婴儿染色体筛查技术,在一定程度上提高了试管婴儿的成功率。
南京军区南京总医院也有很多经验丰富的专业生殖专家。他们擅长治疗各种原因引起的不孕不育,对试管婴儿技术的临床和实验室操作熟练,能让每一对去看病的不孕不育夫妇更放心。
全国十大试管婴儿医院排名中有南京鼓楼医院吗?
1.郑州大学第一附属医院
2.北京大学第三医院
3.中信湘雅生殖遗传医院
4.山东大学附属生殖医院
5.中山大学第一附属医院
6.南京鼓楼医院
7.华中科技大学同济医学院附属同济医院
8.重庆妇幼保健院
9.江苏省人民医院
10.上海交通大学医学院附属仁济医院
从以上试管婴儿医院排名不难发现,在我国十大试管婴儿医院中,南京鼓楼医院的成功率如何?
南京鼓楼医院做试管婴儿的成功率怎么样?
南京鼓楼北医院隶属于南京鼓楼医院,建于1892年,是中国最早的西医医院之一。南京鼓楼北医院生殖医学中心位于中山北路,医疗室面积6万间m2、按卫生部要求设置辅助生殖技术手术室.净化培养室.胚胎冰箱和其他20多个功能室。这是许多不孕症患者选择的医院,实现了许多不孕症夫妇成为父母的愿望。2015年,南京鼓楼生殖科北院新鲜胚胎移植周期临床妊娠率高达68%.26%,临床妊娠率和分娩率继续保持国际领先水平。新鲜胚胎移植周期单囊胚移植周期临床妊娠率60%.双囊胚移植周期临床妊娠率为70%.59%。
南京鼓楼医院生殖中心有哪些试管专家?
1.孙海翔医生
孙海翔医生是南京鼓楼医院生殖医学中心主任医师,江苏省妇产科学会副主任委员.中华医学会生殖分会实验室学组副组长.中华医学会生殖医学分会会员兼副秘书长。
2.周建军医生
周建军医生是南京鼓楼医院生殖医学中心主任医师,擅长不孕症和生殖内分泌疾病的诊断和治疗.慢性输卵管炎.输卵管积水.多囊卵巢综合征.子宫内膜异位症.不明原因不孕.复发性自然流产、染色体异常等疑难杂症的诊治。
3.胡雅莉医生
胡亚丽医生是南京鼓楼医院生殖医学中心主任医师。他从事妇产科临床工作30多年。他擅长妇科内分泌疾病和不孕症的诊断和治疗,特别是排卵和试管受精、妊娠保健、遗传咨询和老年妊娠诊断和治疗。
以上就是关于“全国十大试管婴儿医院排名中有南京鼓楼医院吗?的相关内容,在全国十大试管婴儿医院排名当中,南京鼓楼医院正在其中,因为这家医院的试管婴儿成功率是比较高的,所以才能排名才会这么好。
网友经历
温馨提示
南京暂时还没有能做第三代试管婴儿的医院,河南省可开展辅助生殖技术的医院,大多能做第一、第二代试管婴儿的医院都分布在郑州、洛阳、新乡、开封等城市,其中郑州大学第一附属医院、河南省人民医院、郑州大学第三附属医院等还是河南省内少有的几家能做第三代试管婴儿的医疗机构。 |
| 试管婴儿痛苦打针经历_试管婴儿费用大约多少_41岁大龄再备孕“二胎”,河东 |
|
| 去泰国做试管要多久?,泰国试管婴儿试管周期是多久 |
|
| 第三代试管婴儿费用_试管婴儿成功率泰悦_去美国做试管婴儿的周期需要多久? |
|
| 试管婴儿龙凤胎选性别_试管婴儿哪家好_营口高龄试管婴儿医院三代成功率是多 |
|
| 试管婴儿成功率有多少_三代试管男孩多女孩多_湖北试管_三峡大学附属仁和医院 |
|
| 第三代试管婴儿选择性别原理_供精试管成功率会高一些吗_关于冷冻胚胎,法官 |
